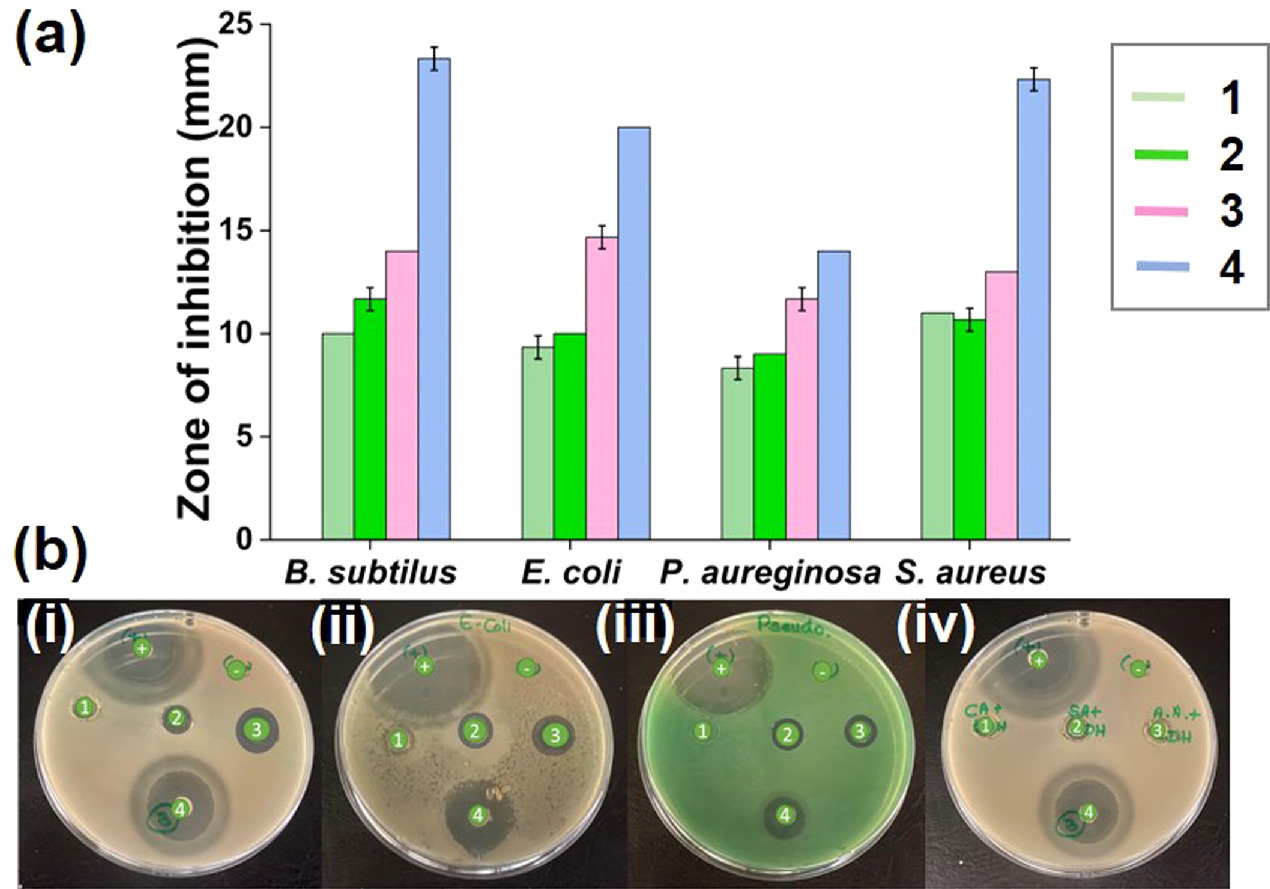
Figure 9.
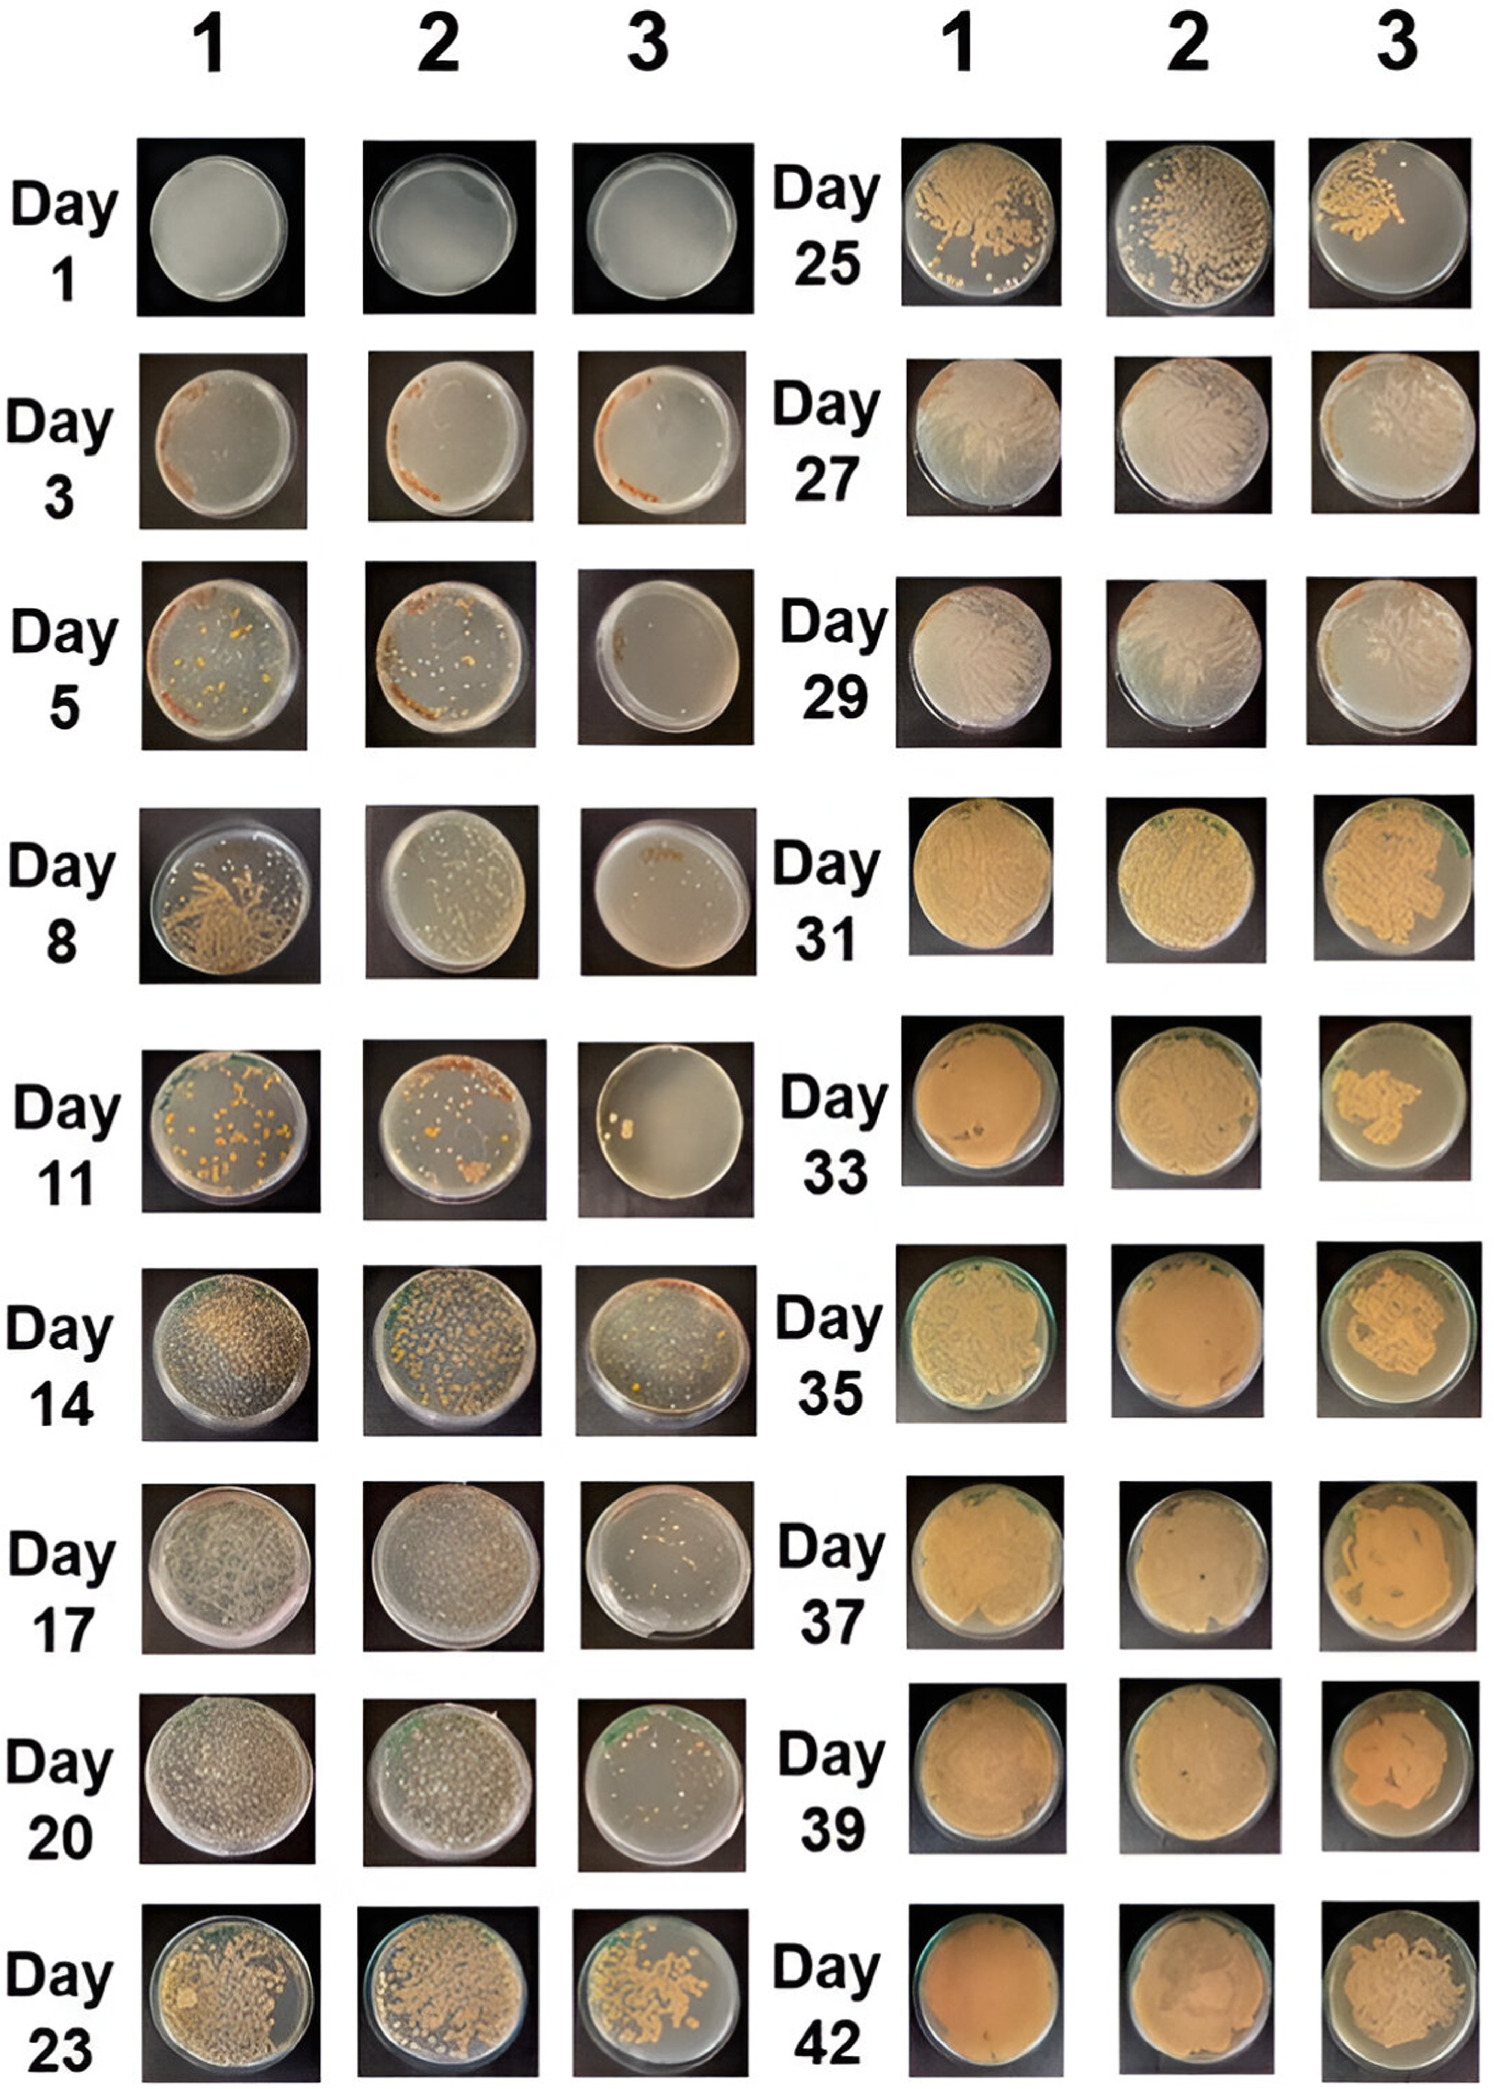
Figure 12.

Abstract
Perishable food post-harvest loss is a major global concern, and research is currently concentrated on creating active packaging materials. This research is focused in multiple antioxidants intercalated Layered Double Hydroxides (LDH) that are combined in one matrix, and their overall effect that defines as synergism, which successfully preserves perishable food by releasing antioxidants slowly. For this purpose, a hybrid LDH material of ascorbic-LDH (AA-LDH), salicylic-LDH (SA-LDH), and citric-LDH (CA-LDH) was synthesized, characterized and incorporate into electrospun nanofiber mat to be used as a potential active packaging material. Antioxidants intercalated Mg/Al LDH was synthesized and successfully characterized by PXRD, FTIR, XPS, Raman, SEM, and EDS. The shifts in the LDHs' peaks in PXRD indicated the successful incorporation of antioxidants into LDH. FTIR, Raman, and XPS data clearly indicated the establishment of metal-oxygen bonds by observing the characteristic peaks. Morphological features and the layered structure were clearly observed by SEM images. Antioxidants were slowly released from the LDHs, and it was evaluated for time intervals up to 24 h. The hybrid LDH material exhibited the highest antioxidant activity with an IC50 value of 132.5 μg ml−1, where 234.1, 354.5, and 402.2 μg ml−1 were reported for ascorbic-LDH, salicylic-LDH, and citric-LDH respectively. The hybrid LDH material incorporated electrospun mats showed the best antibacterial activity against the tested bacteria and clearly evidenced the synergistic activity of the combination of the nanohybrids. It has showed a minimal bacterial growth compared to the other control samples (∼2.41 log CFU/ml). The shelf life of cherry tomatoes was studied at different physiochemical parameters with and without hybrid LDH material incorporated electrospun mats. The fabricated mat showed an extended shelf life of 42 days for cherry tomatoes, whereas the control sample showed a shelf life of 17 days. It is concluded that hybrid LDH material exhibited synergistic performance and the best antioxidant activity when comparing with mono LDH materials.
Export citation and abstract BibTeX RIS

Original content from this work may be used under the terms of the Creative Commons Attribution 4.0 licence. Any further distribution of this work must maintain attribution to the author(s) and the title of the work, journal citation and DOI.
1. Introduction
Consumers around the world are demanding more nutritious, fresh foods, and the food industry is under increasing pressure to provide this need. At the same time, food safety regulations are getting tougher. In order to prevent any unwanted changes in quality, foodstuffs are packaged and handled hygienically before they are supplied to the end user [1–3]. The packaging of food is constantly evolving to meet the demands of consumers and new developments in nanotechnology. Customers in competitive market today want food that is ready to eat that has a long shelf life, is naturally high-quality, and is guaranteed safe [4]. Not only innovative packaging techniques can improve consumer engagement, but they also provide effective distribution and preservation during transit. Technological developments in food packaging in the 21st century have been greatly influenced by the scientific knowledge of nanomaterials, often referred to as nanotechnology [5]. Using nanotechnology, materials of scientific and economic value can be created and controlled at the nanoscale. Since nanotechnology was introduced to the food packaging sector, concerns regarding safety, quality, and stability have been substantially decreased [6]. Research into the use of nanotechnology for the sustained release of preservatives and antimicrobials has been conducted in an effort to extend the shelf life of the product within the packaging. These efforts into the potential benefits of using nanotechnology in food packaging has quickly become an area of high academic priority. The use of nanoparticles in food packaging has been well-received by customers as well as retailers due to the improved mechanical and barrier properties and enhanced food preservation that provide [7, 8].
Due to their superior physicochemical features as adsorption materials, Layered Double Hydroxides (LDHs) have recently attracted a great deal of interest among nanomaterials in the comprehensive study of layered functional materials [9]. Exchangeable anions along with water molecules are sandwiched by positively charged in the stacked layered framework of LDHs [10]. Positively charged plates result from the substantial and isostructural replacement of trivalent cations for di valent cations within the layers. The positive charges in the interlayer LDH regions are balanced by intercalating anions. Furthermore, according to several researches, LDHs have a water-resistant arrangement, a high acid–base buffering capability, and the ability to be reused for several adsorption–desorption sessions [11, 12]. Advantages of LDH materials, especially Mg/Al LDH, include low production costs, biocompatibility, and less toxicity to mammalian cell mats [13]. Numerous therapeutic substances, such as antioxidants, antibacterial, preservatives, and anti-inflammatory medications, are efficiently transported and intercalated by LDHs, according to previous study [14].
Added ingredients to food, known as 'farm to plate' preservatives, whether natural or artificial, work to prevent oxidative deterioration during manufacturing and storage [15]. Antioxidants contribute to the preservation of nutrients, texture, color, sensation of taste, freshness, performance, odour, and attractiveness to consumers. This is because they have high durability and low volatility. The primary cause of food spoilage subsequent to the development of microbes, is lipid oxidation [16]. Foods with a large amount of lipids, particularly those with a high degree of unsaturation, are especially vulnerable to deterioration via this mechanism. Foods that have undergone lipid oxidation yield rancidity-related off flavors, rendering them unfit for human consumption. Further negative implications include the generation of toxic aldehydes and the breakdown of PolyUnsaturated Fatty Acids (PUFAs), resulting in a decline in nutritional quality [17].
The quest for natural and secure antimicrobial compounds that can regulate pathogenic bacteria like Escherichia coli and Staphylococcus aureus in the food sector has been spurred by the increased need for security when handling food [18–21]. There is substantial evidence that the antioxidant, antibacterial, and anti-inflammatory effects of natural Organic Acids (OAs). Some exogenous natural OAs have recently shown promise in postharvest fruit quality management and shelf life extension [22]. Salicylic acid does, in fact, work well to inhibit postharvest fungal diseases in fruit and vegetables, including Penicillium expansum, Botrytis cinerea, Fusarium oxysporum, and Rhizopus stolonifer. Furthermore, using the subjective disc diffusion technique, a number of research investigations have demonstrated the inhibitory effectiveness of starch- or chitosan-based coatings integrated with salicylic acid as an active ingredient towards isolates of bacteria such as S. aureus, E. coli, and Bacillus subtilis [23].
Ascorbic acid, also referred to as vitamin C, is an organic molecule that is a member of the monosaccharide category [24]. When ascorbic acid comes into contact with oxygen, it exhibits a strong oxidation propensity. Furthermore, ascorbic acid can counteract free radicals to prevent the development of detrimental chain reactions that could otherwise affect living things [25, 26]. It permits the preservation of other crucial components in organisms and diets, such as thiamine, folic acid, vitamin A, and vitamin E [27].
Another important antioxidant is citric acid. Its acidic pH makes it an effective food preservative that significantly reduces oxidation to preserve food color. Many meals are regularly enhanced with citric acid since many microorganisms cannot survive in an acidic environment. Antioxidants can interact antagonistically, additively, or synergistically, among other ways. The concept of synergism states that a combination of antioxidants can increase oxidative damage stability more successfully than the combined effects of each antioxidant alone [28]. Synergism is affected by a wide range of factors, including the type of food framework, pH, antioxidant category, concentration, and ratio, connections with other food components, and manufacturing characteristics. Several investigations have demonstrated synergistic connections between lycopene and vitamin E [29], myricetin and kaempferol [30], and resveratrol and catechin [31]. If we understand the underlying principles of synergism and the components that can create this synergism, it will be easier to establish which antioxidant combinations will function in different food systems [32]. This is especially true if we don't need to do numerous trials to screen antioxidant blends. As a result, we combined three antioxidants in our study—salicylic acid, ascorbic acid, and citric acid—and showed how they worked in combination.
Electrospinning is a straightforward and adaptable method for encapsulation of several natural active components. Electrospinning has the potential to efficiently trap and transport bioactive/natural molecules because it does not require extreme temperature or pressure conditions or the use of strong chemicals. Electrospinning is now being utilized in the food industry to encase active substances in various biopolymers, safeguarding them from harsh environmental conditions, preserving their health benefits, and enabling regulated release. Electrospinning presents a new opportunity in food technology that may soon be commercialized [33].
The electrospun nanofiber is considered the most suitable option for immobilizing antioxidants on a solid inert substrate due to its unique three-dimensional porous nature, highly efficient surface area, and flexibility during use, resulting in the desired morphological structure [34]. Electrostatic forces are used in the straightforward, recently invented process of electrospinning to create ultrathin, nanoscale fibers. Compared to other methods, electrospinning yields mats with a higher surface area to volume ratio. Furthermore, the electrospun nanofiber mat guarantees the antioxidants' reusable nature because of their fibrous structure, which makes it more difficult to separate the powdered antioxidants from the reaction mixture [35].
To guarantee the safety and genuineness of food products throughout the supply chain, various stakeholders such as food manufacturers, sellers, consumers, and government agencies are seeking a new, fast, simple, and dependable method to monitor the quality of packaged food. This complements the traditional passive barrier hypothesis [36]. Therefore, the goal of this research is focused on a development of polymer-based nanofiber mat reinforced with common antioxidants for food packaging. Three antioxidants—CA, SA, and AA—were employed to achieve synergy. This mixture of antioxidants was intercalated to Mg/Al LDH system to provide a slow-releasing effect since this food packaging material should remain active throughout its shelf life. Finally, electrospinning integrated the synthesized nanomaterial into naofibrous mat. Figure 1 depicts an overview of this research. According to the published data, this is the first effort that has been proved the synergistic activity of antioxidants as food preservatives.
Figure 1. Overview of the research.
Download figure:
Standard image High-resolution image2. Materials and method
2.1. Materials
All reagents and other chemicals, including magnesium nitrate, aluminium nitrate, sodium nitrate, ascorbic acid, citric acid, salicylic acid, trisodium citrate, sodium carbonate, sodium hydroxide, 2,2 diphenyl-1-picrylhydrazil (DPPH), methanol, acetone, dimethylformamide, cellulose acetate, sodium chloride, barium chloride, and sulfuric acid were purchased from Sigma Aldrich, USA. Chemicals, media, and other materials for microbiology research, such as nutritional agar, Muller Hinton agar, Muller Hinton broth agar, bacteriological agar, and antibiotic powders, were obtained from Himidia in India. All compounds were used, including the analytical grade as obtained. ATCC strains of gram-positive bacteria Staphylococcus aureus (ATCC 25923), Bacillus subtilis (ATCC 49619), and gram-negative bacteria Escherichia coli (ATCC 25922), and Klebsiella pneumoniae (ATCC BAA 1706) were obtained from the Department of Microbiology, University of Sri Jayewardenepura, Sri Lanka.
2.2. Instrumentation
In order to analyze the functional groups and relevant peak positions, the synthesized nanohybrids were subjected to fourier transform infrared (FTIR) analysis—KBr method (Bruker Vertex 80 instrument) within the range (400 cm−1 to 4000 cm−1) and Raman spectroscopic analysis (Thermo scientific DXR Raman Spectroscopy, Fine laser power) within the range of 500 cm−1–2500 cm−1. The crystalline structures of the nanohybrids were analyzed by x-ray diffraction (XRD) analysis (Rigaku smart lab, 3 kW sealed x-ray tube, CBO optics, D/teX Ultra 250 silicon strip detector) within the range 4-70, 2 theta degrees by using the software; SmartLab Studio II. The morphology of the hybrid LDH and the nanofiber mats were analyzed by scanning electron microscopy (SEM) imaging (ZEISS model, mode of secondary electron, at an accelerating voltage of 10 kV). Image J software (Image J 1.51) was used to measure the diameter and its distribution curve of the hybrid LDH incorporated nanofiber mat. Energy dispersive x-ray spectrometry analysis (EDS) was performed parallelly with the SEM imaging to assess the chemical composition. UV–vis spectrometric analysis (Perkin Elmer) was used to perform the release studies of the antioxidants and the DPPH assay. x-ray photoelectron spectroscopic (XPS) analysis (Thermo scientific TM ESCALAB Xi+ apparatus) was further carried out for hybrid LDH in order to analyse the elemental composition. First, the survey spectra for all the samples were obtained. Then the individual spectral peaks were examined at higher energy resolution to identify the chemical composition and the electron configurations of atoms. The spectra, which were taken at high resolution are further processed by the software - Thermo Advantage, version-5.982 by removal of background and the curve fitting of individual peaks alone with a Gaussian/ Lorentzian function. A monochromic x-ray beam that originated at 1486.6 eV by an Al Kα source was used for the analysis.
2.3. Synthesis of LDH materials
The synthesis of LDH materials was carried out using the co-precipitation technique, as previously reported in the literature [37]. Here, five types of LDH materials were synthesized including nitrate-LDH, AA-LDH, SA-LDH, CA-LDH and combination of AA, CA and SA-LDH (hybrid LDH). Nitrate-LDH was synthesized by adding a solution containing 0.125 mol of Al(NO3)3.9H2O and 0.25 mol of Mg(NO3)2.6H2O in 250.00 ml of distilled water dropwise to a solution containing 0.25 mol of NaNO3 in 100.00 ml of distilled water while vigorously swirling at room temperature. Throughout the experiment, a 2.0 mol dm−3 NaOH solution was used to maintain the pH at 10. The solution was then agitated for six hours in an inert atmosphere. The precipitate was centrifuged three times with distilled water to remove excess NaOH, then dried at 90 °C for 12 h.
The AA-LDH, CA-LDH, and SA-LDH were synthesized as same as nitrate LDH by using the conditions mentioned below (table 1). Finally, all the LDH materials were dried separately at 90 °C for 12 h.
Table 1. Conditions to synthesize AA-LDH, CA-LDH, and SA-LDH.
| Concentration of Mg(NO3)2.6H2O | Concentration of Al(NO3)3.9H2O | Concentration of acid | Concentration of NaOH | pH | |
|---|---|---|---|---|---|
| AA-LDH | 0.44 moldm−3 (25.00 ml) | 0.22 moldm−3 (25.00 ml) | 0.5 moldm−3 (100 ml) | 1.5 moldm−3 | 9 |
| CA-LDH | 1 moldm−3 (25.00 ml) | 0.5 moldm−3 (25.00 ml) | 2.55 moldm−3 (25.00 ml) | 2.0 moldm−3 | 10 |
| SA-LDH | 0.44 moldm−3 (25.00 ml) | 0.22 moldm−3 (25.00 ml) | 0.5 moldm−3 (100 ml) | 1.5 moldm−3 | 9 |
Synthesized AA-LDH, CA-LDH, and SA-LDH were combined in equal molar ratios by manual grinding to formulate the hybrid LDH material.
2.4. Determination of intercalated fractions of each antioxidant to the LDH
The deintercalation experiment was conducted using the ion exchange method [38]. For the de-intercalation of ascorbic acid, citric acid, and salicylic acid from the intercalated LDHs; 50.00 ml of 0.05 mol dm−3 Na2CO3 solution was placed in three separated 100.00 ml erlenmeyer flasks. Then 15 mg of each intercalated LDH was added into each flask. It was stirred (300 rpm) at room temperature for 24 h. The suspension was then separated by centrifugation. The supernatant solution was collected, and the de-intercalated acid concentration was determined using a UV-Visible spectrophotometer at 265 nm, 210 nm, and 231 nm for ascorbic acid, citric acid, and salicylic acid, respectively.
2.5. Preparation of electrospun nanofiber mats
2.5.1. Preparation of cellulose acetate nanofiber mat
An amount of 600 mg of cellulose acetate was taken into a glass vial. Then acetone: DMF were added in a 2:1 V/V ratio, such that 4 ml of acetone and 2 ml of DMF. The mixture was stirred for 6 h using a magnetic stirrer for the successful dispersion of cellulose acetate with acetone and the DMF solvent system. After the preparation of the polymer solution, 6 ml of the prepared solution was loaded into a syringe attached to a needle. Aluminium foil was spread on the collector plate. The process was started after setting the electrospinning parameters and continued for about 4 h. The electrospinning parameters were; voltage of 16 kV, flow rate of 1.5 ml h−1, distance between the spinneret and the collector of 13 cm, temperature of 30 °C and humidity of 78% [39].
2.5.2. Preparation of 40% (w/w) nitrate-LDH embedded nanofiber mat
An amount of 600 mg of cellulose acetate and 400 mg of nitrate-LDH were taken into two separate glass vials. Then acetone and DMF were mixed in a 2:1 V/V ratio, such that 4 ml of acetone and 2 ml of DMF. It was separated into 2 portions (3 ml), and one portion was added into the glass vial, which contains cellulose acetate, and the other portion was added to the nitrate-LDH. Both solutions were stirred for 2 h, and then both were mixed and again stirred for another 4 h. The electrospinning was then carried out as described previously.
2.5.3. Preparation of 40% (w/w) AA-LDH, CA-LDH, and SA-LDH nanohybrids embedded nanofiber mat
A polymer solution for the preparation of a 40% (w/w) AA-LDH embedded nanofiber mat was prepared. 600 mg of cellulose acetate and 400 mg of AA-LDH were taken into two separate glass vials. Then acetone and DMF were mixed in a 2:1 v/v ratio such that 4 ml of acetone and 2 ml of DMF. It was separated into 2 portions (3 ml) and one portion was added into the glass vial, which contains cellulose acetate, and the other portion was added to the AA-LDH. Both solutions were stirred for 2 h, and then both were mixed and again stirred for another 4 h. Before the electrospinning, the solution was sonicated for about 40 min for better dispersion. The electrospinning was then carried out as described previously.
The aforementioned procedure was repeated to fabricate the CA-LDH embedded, SA-LDH embedded, and combination of all the nanohybrids embedded electrospun mats.
2.6. DPPH IC50 assay for LDH materials
Antioxidant activity of nitrate-LDH, AA-LDH, CA-LDH, SA-LDH, hybrid LDH material, pure ascorbic, pure salicylic, pure citric, and mixtures of pure acids was measured using the DPPH (2,2-diphenyl-2-picryhydrazyl) assay method and IC50 value was calculated [40]. Concentrations series of 9.125, 18.25, 37.5, 75, 150, 300, 600, and 1200 μM ml−1 was prepared by dispersing each material in distilled water. Then 1 ml of 100 μM DPPH solution prepared in methanol was added to 1 ml of each solution. The mixtures were shaken vigorously and incubated in the dark for 30 min at ambient temperature. The decrease in absorbance of the resulting solutions was monitored at 517 nm using a UV–vis spectrometer, and DPPH antioxidant activity and IC50 values were calculated.
2.7. Antibacterial activity of antioxidants intercalated LDH incorporated electrospun polymer mats
The disc diffusion method was conducted to observe the antibacterial action of the antioxidants intercalated LDH incorporated electrospun polymer mats [41, 42]. CA-LDH, AA-LDH, SA-LDH, and hybrid LDH material of all nanomaterials incorporated electrospun mats were tested against the ATCC cultures of gram-positive bacteria; Staphylococcus aureus (ATCC 25923), Bacillus subtilis (ATCC 49619), and gram-negative bacteria; Escherichia coli (ATCC 25922), and Klebsiella pneumoniae (ATCC BAA 1706). These bacteria are predominant pathogenic bacteria that can be commonly observed in food. Commercially available antibiotic discs of Erythromycin (15 μg) were used as the positive control for gram-positive bacteria. Merepenem (10 μg) was used for P.aureginosa, and gentamycin (15 μg) was used for K. pneumoniae. Cellulose acetate electrospun mats was used as the negative control. The diameter of the discs that were used for the assays was 6 mm.
The prepared media (Muller Hinton Agar) and tips of the micropipette were sterilized in an autoclave at 121 °C (15 bar pressure) for 15 min. Other glass ware was sterilized in a hot air oven at 160 °C for 2 h. A quantity of 25 ml of Muller-Hinton agar was poured into each disposable petri dish and allowed to solidify. Then 3 ml of the bacterial suspensions, which are adjusted with their concentrations to 0.5 McFarland's standard (108 CFU ml−1), were dispensed on to the surface of the agar medium. The excess microbial suspension was then carefully removed by using a micropipette. The bacterial suspensions were prepared by using a fresh culture of the aforementioned bacteria. Discs were placed on the surface of the solidified agar by using sterile forceps, and then all the plates were incubated for 24 h at 37 °C. Afterwards, the zone of inhibition for each well was measured (Netillin Zone Reader, USA). All the procedures were triplicated and conducted according to the CLSI guidelines [43].
2.8. Release study of antioxidants from hybrid LDH mixture embedded nanofiber mat
An area of 4 cm2 of hybrid LDH mixture embedded in nanofiber mat was obtained, and it was added to 50 ml of distilled water and stirred at 200 rpm at room temperature. An aliquot of 3 ml was withdrawn after centrifugation of the solution at each specified time period and was replaced with an equal volume of distilled water. The concentration of the released ascorbic acid, salicylic acid, and citric acid was measured using a UV–vis spectrophotometer at 265 nm, 231 nm, and 210 nm respectively, until 24 h at defined time intervals. The same procedure was triplicated using another two 4 cm2 pieces from different two places on the nanofiber mat. The concentrations of the withdrawn aliquots were determined with the aid of a calibration curve that was calculated from standard solutions [37].
2.9. Applying electrospun nanofiber mats for active packaging of cherry tomatoes and conducting shelf life investigations
Freshly harvested cherry tomatoes were selected for the experiment to evaluate the progress of the activity of hybrid LDH material embedded in an electrospun nanofiber mat. Cherry tomatoes were selected in the same size, colour, appearance, and absence of defects. All the selected tomatoes were washed with distilled water and allowed to dry. The initial weights of all the cherry tomatoes were recorded. Then three separate containers were obtained in the same size, and those were cleaned. Hybrid LDH material embedded in an electrospun nanofiber mat was put on the bottom of one container, and 30 tomatoes were placed inside the container. As the positive control, a cellulose acetate nanofiber mat was put on the bottom of the second container, and 30 tomatoes were placed inside the container. As the negative control, another 30 tomatoes were placed inside the third container without any nanofiber mat. Three cherry tomatoes (n = 3) were used for each trial. Then all three containers were covered with lids and kept in storage at 4 °C until 42 days. The physicochemical properties of stored cherry tomatoes were tested on the initial day and then at 3-days intervals [37].
2.10. Evaluation of physiochemical parameters of the cherry tomatoes
2.10.1. Weight loss measurements
Weight of the cherry tomatoes was obtained each day by an analytical balance, and the difference between the initial weight and the final weight was calculated as a percentage of the total weight loss by using the following equation (1).

Where, W0 is the initial weight of tomato and WT is the weight of stored tomato.
2.10.2. Evaluation of the pH measurements
The tomato purees were prepared each day from each sample by crushing the tomatoes. The juice was separated by filtering the puree, and the pH of the samples was recorded using the pH meter.
2.10.3. Determination of titratable acidity
For the determination of titratable acidity, aliquots of 3 ml of tomato juice were transferred into an erlenmeyer flask, diluted up to 50 ml, and graduated with distilled water. A few drops of phenolphthalein indicator were added. Then the sample was titrated against 0.01 moldm−3 NaOH.
2.10.4. Determination of differences of firmness
A BISHOP FT 327 fruit pressure tester (penetrometer) was used to measure the firmness of cherry tomatoes in each sample.
2.11. Microbiological analysis of the shelf-life experiment
The count of colony forming units for both bacteria and molds was recorded according to the bacteriological analytical manual [44, 45]. The sampled cherry tomatoes were crushed separately in sterile containers with sterile forceps and pipetted out 0.5 ml from the crushed juice. They were cultured on previously prepared Muller-Hinton agar plates. Then the plates were incubated at 37 °C for 24 h. The colony forming units for bacteria and molds were recorded for each sample. This procedure was repeated for all the samples at defined time intervals. Microbial counts were expressed as; log CFU/ml for bacterial colony counts and CFU/ml for molds, and the experiment was triplicated.
3. Results and discussion
In this investigation, we aimed to develop a polymer-based nanofiber mats reinforced with commonly used antioxidants that could possibly be applied to food packaging to extend the shelf life of perishable fruits and vegetables. To ascertain the synergistic activity of three types of antioxidants, ascorbic acid (AA), salicylic acid (SA), and citric acid (CA), were used. The antioxidant mixture was subsequently intercalated into the Mg/Al LDH system to produce a gradual release effect and to obtain synergistic activity since the food packaging material's activity ought to endure for the duration of the shelf life of food. To fabricate the electrospun mats, the material was finally electrospun. The electrospun mats were characterized and investigated as a practical application by using it to package cherry tomatoes. Cherry tomatoes have been used as a model fruit to prove the concept of this research.
Packaging is an essential part of every aspect of food production, consequently in order to ensure the security and authenticity of food commodities all over the entire supply chain, manufacturers of food, sellers, consumers, and food government agencies are looking for a new, quick, easy, reliable tool to monitor the quality of the food that is packaged. Hence, this fabricated electrospun mats reinforced with a combination of antioxidants will be an effective, readily available, cost effective, apparently nontoxic, biodegradable, and antibacterial food packaging material.
3.1. Characterization of synthesized antioxidants intercalated LDH
The interlayer spacings of AA-LDH, SA-LDH and CA-LDH were compared against nitrate-LDH using powder x-ray diffraction (PXRD) patterns. PXRD patterns were acquired through reflection from powder samples contained in a sample container. The PXRD patterns were recorded over a 2θ range of 4 to 70 with a scan speed of 2 deg min−1. Figure 2(a) displays the PXRD patterns of nitrate-LDH (figure 2(a-i)), AA-LDH (figure 2(a-ii)), SA-LDH (figure 2(a-iii)) and CA-LDH (figure 2(a-iv)). The pronounced and sharp peaks indicate the crystalline nature of the samples. The prominent primary diffraction peak of the nitrate-LDH was detected at d003 = 7.96 Å [45]. The intercalation of ascorbic, salicylic, and citric acids into the interlayer space of the LDH structure is clearly observed by the increase in the basal spacing (the distance between atomic planes that give rise to diffraction peaks) upon replacing nitrate ions [46].
Figure 2. (a) PXRD analysis of synthesized nanohybrids; (i) Nitrate-LDH, (ii) AA-LDH, (iii) SA-LDH, (iv) CA-LDH, (b) Raman analysis of; (i) Nitrate-LDH, (ii) AA-LDH, (iii) SA-LDH, (iv) CA-LDH, (v) combination of AA-LDH, SA-LDH and CA-LDH.
Download figure:
Standard image High-resolution imageThe (003) reflection peaks shift to lower 2 theta values upon the intercalation of acid molecules. XRD patterns indicates that the intercalation of ascorbic, salicylic, and citric acids into nitrate-LDH rise to an increase in basal spacing from 7.96 Å to 16.21 Å, 15.5 Å and 11.58 Å for AA-LDH, SA-LDH and CA-LDH respectively [46, 47].
The Raman analysis provided evidence of relevant bonds and peak shifts in synthesized LDH nanohybrids (figure 2(b)). Intercalation leads to the formation of new bonds and break the excisting bonds. Because of this phenomenon, peak shifting can be observed in intercalated LDH. When compared with the nitrate-LDH, for anions, intercalated LDHs can form a stronger H-bonding network than the nitrate groups due to the presence of a larger number of carboxylate and hydroxyl groups. This leads to the peak shifting [48]. The spectrum of nitrate-LDH (figure 2(b-i)) shows a peak at 561 cm−1, which corresponds to the vibration of Al-O bonds in the layers of the Mg/Al LDH. The 720 cm−1 band is specifically attributed to the NO3 − ion. The intense peak at 1070 cm−1 can be assigned to Mg-O bonds. However, the peaks have shifted by the intercalation of ascorbic, salicylic, and citric acids into the LDH, and the peak that corresponds to the NO3 - ion is absent in all the intercalated LDHs. In the spectrum of AA-LDH (figure 2(b-ii)) the peak corresponding to the Al-O bonds has shifted to 552 cm−1, and the intense peak corresponding to the Mg-O bond, has shifted to 1050 cm−1 due to the intercalation of ascorbate anions. Also, the intensities of both peaks have decreased in AA-LDH. There is a peak at 951 cm−1, which corresponds to the vibration of C-O bonds and the peak corresponding to the NO3 - ion is absent in AA-LDH. In the spectrum of SA-LDH (figure 2(b-iii)) the peak corresponding to the Al-O bonds has shifted to 549 cm−1, and the intense peak corresponding to the Mg-O bond, has shifted to 1043 cm−1 due to the intercalation of salicylate anions. Also, the intensities of both peaks have decreased. The peak that corresponds to the vibration of C-O bonds is appearing at 809 cm−1 and the peak corresponding to the NO3 - ion is absent [49, 50].
Peaks correspond to the Al-O bonds and the Mg-O bonds have shifted to 551 cm−1 and 1052 cm−1 respectively, in CA-LDH (figure 2(b-iv)). The peak that corresponds to the vibration of C-O bonds is appearing at 842 cm−1 and the peak corresponding to the NO3 - ion is absent. This peak shift confirms the successful intercalation of citrate ions into the LDH. The Raman spectrum of hybrid LDH material (figure 2(b-v)) shows all the peaks that identified in AA-LDH, SA-LDH, and CA-LDH at 548 cm−1, 812 cm−1 and 1041 cm−1 which correspond to Al-O bonds, C-O bonds, and Mg-O bonds, respectively [51].
FTIR spectroscopy analysis was performed on the developed nitrate-LDH, AA-LDH, SA-LDH, CA-LDH, ascorbic acid, salicylic acid, and citric acid to identify functional groups in the materials and build new linkages (figure 3). Intercalation causes the development of new bonds while breaking the existing bonds. This scenario results in broadening and peak shifting in intercalated LDHs. When compared to nitrate-LDH, acid anions in intercalated LDH can form a stronger H-bonding network than nitrate groups due to the presence of more carboxylate and hydroxyl groups.
Figure 3. FTIR analysis of; (a) (i) AA, (ii) Nitrate-LDH, (iii) AA-LDH; (b) (i) CA, (ii) Nitrate-LDH, (iii) CA-LDH; (c) (i) SA, (ii) Nitrate-LDH, (iii) SA-LDH.
Download figure:
Standard image High-resolution imageIn figure 3, nitrate-LDH, the broad peak at 3463 cm−1 is attributable to the hydroxyl stretching modes of the stacked hydroxyl groups, whereas the peak at 1385 cm−1 is assigned to the nitrate group stretching frequency that exists within the layers. The bands present at 625 cm−1 and 448 cm−1 correspond to the lattice vibration modes. These bands can be attributed to metal-oxygen stretches of Mg-O and Al-O. In figure 3(a-i), broad and intense peak is observed at 3413 cm−1 for pure ascorbic acid, which is assigned to the hydroxyl stretching frequency. The intense peak at 1616 cm−1 for pure ascorbic acid is due to the carboxyl stretching modes. The intense broad peak is observed at 3413 cm−1 for ascorbic acid and 3463 cm−1 for nitrate-LDH, which have been shifted to 3431 cm−1 after the intercalation. Sharp peaks observed at 1629 cm−1 and 1384 cm−1 for ascorbic-LDH correspond to the asymmetric and symmetric stretching modes of the carboxylate groups. The stretching vibrations of the carboxylate group of pure ascorbic acid at 1616 cm−1 has been shifted to 1629 cm−1 after the intercalation into layers. That is due to the stronger intermolecular interactions, such as H - bonding and Van Der—Waals interactions, experienced by the intercalated citrate anions within the matrix [52, 53]. Metal-oxygen stretches of Mg-O and Al-O at 625 cm−1 and 448 cm−1 have been shifted to 656 cm−1 and 443 cm−1 after the intercalation of ascorbic acid.
In figure 3(b-i), a broad and intense peak is observed at 3450 cm−1 for pure citric acid, which is assigned to the hydroxyl stretching frequency. The intense peak at 1730 cm−1 for pure citric acid is due to the carboxyl stretching modes. An intense broad peak is observed at 3450 cm−1 for citric acid and 3463 cm−1 for nitrate-LDH, have been shifted to 3451 cm−1 after the intercalation. Sharp peaks observed at 1590 cm−1 and 1384 cm−1 for citric-LDH correspond to the asymmetric and symmetric stretching modes of the carboxylate groups. The stretching vibrations of the carboxylate group of pure citric acid at 1730 cm−1 has been shifted to 1590 cm−1 after the intercalation into the layers. That is due to the stronger intermolecular interactions, such as H - bonding and Van Der—Waals interactions, experienced by the intercalated citrate anions within the matrix [54]. Metal-oxygen stretches of Mg-O and Al-O at 625 cm−1 and 448 cm−1 have been shifted to 619 cm−1 and 447 cm−1 after the intercalation of citrate ions [54].
In figure 3(c-i), peaks were observed at 3516 cm−1–3238 cm−1 for pure salicylic acid, which is assigned to the hydroxyl stretching frequency. The intense peak at 1660 cm−1 for pure salicylic acid is due to the carboxyl stretching modes. An intense broad peak is observed at 3463 cm−1 for nitrate-LDH, and peaks observed at 3516 cm−1–3238 cm−1 for pure salicylic acid have been shifted to 3470 cm−1 after the intercalation. Sharp peaks observed at 1606 cm−1 and 1384 cm−1 for salicylic-LDH correspond to the asymmetric and symmetric stretching modes of the carboxylate groups. The stretching vibrations of the carboxylate group of pure salicylic acid at 1660 cm−1 have been shifted to 1606 cm−1 after the intercalation into layers. That is due to the stronger intermolecular interactions, such as H - bonding and Van Der—Waals interactions, experienced by the intercalated salicylic acid anions within the matrix [55]. Metal-oxygen stretches of Mg-O and Al-O at 625 cm−1 and 448 cm−1 have been shifted to 665 cm−1 and 447 cm−1 after the intercalation of salicylic acid.
The nature of the molecular interactions between the layers of the LDH and acid anions was studied by x-ray photoelectron spectroscopy (XPS). The binding energies of Al 2p, C 1s, Mg 1 s, and O 1 s electron configurations in the nitrate-LDH, SA-LDH, CA-LDH, and AA-LDH were specifically shown in figure 4. When compared with nitrate-LDH, the inserting of SA, CA, and AA into the interlayer space of LDH caused an increase in Al 2p and Mg 1 s binding energy, indicating an alteration of the bonding environment [56]. These shifts account for the electrostatic interactions that occurred between Al3+ and Mg2+ due to the formation of new bonds between the hydroxide layers of the LDH and acid anions through the oxygen atoms. These chemical shifts occur due to the variations in the electrostatic screening that the core electrons experience when valence electrons are either drawn toward or moved away from the atom. It will result in a decrease in electron density around Al3+ and Mg2+ and an increase in binding energies [57].
Figure 4. XPS deconvoluted high resolution spectra of; (a) C 1 s; (b) O 1 s; (c) Mg 1s and (d) Al 2p; (1) nitrate-LDH, (2) SA-LDH, (3) CA-LDH and (4) AA-LDH.
Download figure:
Standard image High-resolution imageFigure 4(a) shows the binding energy differences of C 1 S state. In this spectrum, it can be clearly observed that there are two significant peaks that governs two atomic configurations of the C 1 s state; the peaks at 282–284 cm−1 are responsible for sp2 C, and the peaks at 286–288 cm−1 are responsible for the binding energy of C in C-O bonds. Here also, it is clearly visible that there are peak shifts due to the intercalation of antioxidants with the LDH. Figure 4(b) shows the binding energy differences of O 1 s state of all the samples. This spectrum also provides evidence of shifting the peak to low or high energy zones due to the intercalation of antioxidants in the LDH. In figure 4(c) the peak at 1302.55 eV that governs the Mg 1 s electron configuration in nitrate-LDH has shifted to 1302.70 eV, 1303.05 eV, and 1302.95 eV in SA-LDH, CA-LDH, and AA-LDH, respectively. In figure 4(d), the peak at 72.45 eV that governs the Al 2p electron configuration in nitrate-LDH has shifted to 72.60 eV, 72.85 eV, and 73.25 eV in SA-LDH, CA-LDH, and AA-LDH respectively [58, 59].
Surface morphological analysis of nitrate-LDH, AA-LDH, SA-LDH, and CA-LDH was done using a scanning electron microscope (SEM). As evidenced by the images shown in figure 5, all the synthesized LDHs demonstrated a typical layered structure containing nanometer size thick platelets (marked in arrows). The morphology of the plate-like particles is roughly hexagonal-shaped, and considerable variation in particle size was detected during SEM analysis. The irregular shape of all the LDHs could be clearly observed in the images [60].
Figure 5. SEM images of; (a) nitrate-LDH, (b) SA-LDH, (c) CA-LDH, (d) AA-LDH.
Download figure:
Standard image High-resolution image3.2. Determination of intercalated percentage of antioxidants to the LDH
The intercalated percentages of AA-LDH, CA-LDH, and SA-LDH were calculated. The deintercalation of each acid from the LDHs by the ion exchange with CO3 2− was investigated in order to release the intercalated ascorbic acid, citric acid, and salicylic acid. CO3 2- ions will replace acid anions due to their highest affinity towards the layers of LDH [37]. According to the obtained results, the loading percentages of AA-LDH, CA-LDH, and SA-LDH were 62.5%, 81%, and 88%, respectively. The highest loading capacity of SA-LDH compared to the other two LDHs may be attributed to a stronger interaction of the brucite-like sheets with the intercalated form of salicylic acid [61].
After the structural and morphological characterization of synthesized LDH nanohybrids, the intercalated percentages of each antioxidant in the LDH were evaluated as described above. Then the combination of all three types of antioxidants intercalated LDH was formulated by combining each antioxidant intercalated LDH in an intercalated percentage-based ratio. It ensured that the sample of the combination of all nanohybrids contained equal quantities of each antioxidant.
3.3. Determination of IC50 values for synthesized LDH nanohybrids by DPPH assay
The DPPH (2,2-diphenyl-1-picrylhydrazyl) assay is a widely used method for measuring the antioxidant activity of various materials. It relies on the ability of antioxidants to scavenge the stable DPPH radical, which changes colour from purple to yellow when neutralized. The antioxidant activity of AA-LDH, SA-LDH, and CA-LDH and the synergistic effect of the hybrid LDH material were determined by DPPH degradation test. IC50 stands for 'half maximal inhibitory concentration.' It defines the concentration of an antioxidant substance required to scavenge 50% of the initial DPPH radicals [62]. It's a measure of the potency of an antioxidant. Lower IC50 values indicate stronger antioxidant activity.
The antioxidant activity of nitrate-LDH, AA-LDH, SA-LDH, CA-LDH, and hybrid LDH material was measured using the DPPH assay method and IC50 value was calculated. Figures 6(a)–(e) shows the constructed IC50 graphs for each LDH. As seen in figure 6(c), the hybrid LDH material exhibited the highest antioxidant activity with an IC50 value of 132.5 μg ml−1, and its synergistic action was validated by the IC50 values of each component, which are 234.1 μg/ml, 354.5 μg ml−1, and 402.2 μg/ml for AA-LDH, SA-LDH, and CA-LDH respectively.
Figure 6. Inhibition versus concentration graph of (a) nitrate-LDH, (b) AA-LDH, (c) hybrid LDH material, (d) CA-LDH and (e) SA-LDH.
Download figure:
Standard image High-resolution imageThe evaluated IC50 values were used to determine the quantities for the electrospun process. Regarding the fabricated electrospun mats, five types of electrospun mats; Cellulose acetate mat (CAc), SA-LDH incorporated CAc, CA-LDH incorporated CAc, AA-LDH incorporated CAc and combination of all nanohybrids incorporated CAc were fabricated. The incorporated quantity of each antioxidant intercalated LDH was higher than their evaluated IC50 values because IC50 value is the concentration of an antioxidant substance required to scavenge 50% of the initial DPPH radicals.
3.4. Characterization of fabricated electrospun mats
As shown in the figure 7, the fabricated nanofiber mats were subjected to XRD analysis. The significant two peaks at the 2 theta positions of 17 and 21 degrees clearly indicate the presence of cellulose acetate [63]. These two peaks can be clearly observed in all the fabricated nanofiber mats, especially in the CAc mat (figure 7(b-i)). In the nanohybrids incorporated nanofiber mats, these peaks have shifted due to the incorporation of nanohybrids into the CAc nanofiber mat. Figure 7(c) shows the Raman analysis of fabricated nanofiber mats. In the cellulose acetate mat (figure 7(c-i)), three significant peaks can be clearly observed at 505, 816, and 1172 cm−1 which govern C-C, C-H out of plane, and C-H out of plane bending vibrations, respectively. In the other four spectra of antioxidant incorporated nanofiber mats, these peaks have shifted due to the same reason of intercalation of nanohybrids into the electrospun mats. When considering the FTIR analysis of electrospun mats, there are five significant peaks (labeled as a-e) in all the electrospun mats. In the CAc nanofiber mat, these five peaks at 3431, 1738, 1231, 1039, and 574 cm−1 which govern O-H, C=O, C-O-C, and C-H out of plane bond vibrations. These peaks have shifted in the other four spectra due to the incorporation of nanohybrids into the CAc nanofiber mat. Considering these reported results, it can be concluded that the successful incorporation of antioxidants intercalated LDH into the cellulose acetate nanofiber mats. Moreover, the significant peaks that have been observed in the LDH nanomaterials have masked in these spectra due to the high intensity of the peaks associated with cellulose acetate [64, 65].
Figure 7. (a) A digital photograph of the fabricated electrospun mats; (b) XRD analysis; (c) Raman analysis; (d) FTIR analysis of; (i) cellulose acetate nanofiber mat (CAc mat), (ii) SA-LDH incorporated CAc mat, (iii) CA-LDH incorporated CAc mat, (iv) AA-LDH incorporated CAc mat, and (v) hybrid LDH material incorporated CAc mat, (e) SEM images of; (i) CAc electrospun mat, (ii) hybrid LDH material embedded nanofiber mat, (f) distribution of the fiber diameter of; (i) CAc electrospun mat and (ii) Hybrid LDH material embedded nanofiber mat.
Download figure:
Standard image High-resolution imageFigure 7(e) shows the morphological characterization of the fabricated nanofiber mats. Figure 7(e-i) shows the fiber morphology of the cellulose acetate nanofiber mat, and the figure 7(e-ii) shows the fiber morphology of nanohybrids incorporated into nanofiber mat. It can be seen that beads are formed along with the fiber that is normally considered to have defects. Also, it can be observed that fiber diameter has been reduced with the incorporation of nanohybrids. The addition of antioxidants intercalated with LDH resulted in the accumulation of a higher charge density on the surface of the ejected jet during electrospinning, and the overall charges carried by the electrospinning jet significantly increased. As the charges carried by the jet increased, higher elongation forces that could overcome the self-repulsion were brought down to the jet under the electric field. Thus, as the charge density increased, the diameter of the fibers became smaller. The SEM images were then analyzed by the software Image J to obtain the mean diameter of the electrospun fibers and to investigate the distribution of fiber diameter (figures 7(f-(i), and (iii)). The mean diameters of the fibers were 114 and 94 nm, which belong to the cellulose acetate mat, and nanohybrids incorporated the cellulose acetate mat [66, 67].
3.5. Release studies of antioxidants from hybrid LDH mixture embedded nanofiber mat
The release behavior of antioxidants from a hybrid LDH mixture embedded in a nanofiber mat was evaluated in distilled water for time intervals up to 24 h. The absorption values of aliquots were measured by using a UV−visible spectrometer at 265 nm, 210 nm, and 231 nm for ascorbic acid, citric acid, and salicylic acid, respectively [68]. In this release study, distilled water was chosen as the medium. In the actual application on the fruit surface, the active substance should be slowly released to the fruit surface in a moist environment. The mechanism involves the diffusion of water molecules into the matrix due to swelling and then matrix relaxation due to the subsequent diffusion of the active compound. Figure 8(a) shows the release profile of ascorbic acid from the hybrid LDH material embedded in a nanofiber mat. Ascorbic acid is present on both the surface and interlayers and is weakly bound to LDH, gradually releasing out in a slow-release manner for up to 9 h. About 80% of the loaded ascorbic acid weight percentage was released after 24 h. When compared to the release curve of ascorbic acid from the pure ascorbic acid embedded nanofiber mat, it shows about 80% load release in about 3 h. This will confirm the sustained release of the active molecules from the LDH.
Figure 8. Release profile of (a) ascorbic acid, (b) salycylic acid, (c) citric acid from nanofiber mats; (Black) From hybrid LDH mixture embedded nanofiber mat and (Red) From pure acid mixture embedded nanofiber mat.
Download figure:
Standard image High-resolution imageFigure 8(b) shows the release profile of salicylic acid from the hybrid LDH material embedded in the nanofiber mat. About 81% of the loaded salicylic acid weight percentage was released after 24 h. Salicylic acid is present on both the surface and interlayers and is weakly bound to LDH, gradually releasing out in a slow-release manner for up to 7 h. When compared to the release curve of salicylic acid from the pure salicylic acid embedded nanofiber mat, it shows about 80% load release in about 1 to 2 h. This will confirm the sustained release of the active molecules from the LDH.
Figure 8(c) shows the release profile of citric acid from the hybrid LDH material embedded in the nanofiber mat. About 62% of the loaded citric acid weight percentage was released after 24 h. Citric acid is present on both the surface and interlayers and is weakly bound to LDH, gradually releasing out in a slow-release manner up to 10 h. When compared to the release curve of citric acid from the pure citric acid embedded nanofiber mat, it shows about 60% load release in about 2 h. This will confirm the sustained release of the active molecules from the LDH.
3.6. Evaluation of antibacterial activity of antioxidants intercalated LDH incorporated electrospun nanofiber mats
The disc diffusion method was conducted to observe the antibacterial action of the antioxidants intercalated LDH incorporated electrospun polymer mats. CA-LDH, AA-LDH, SA-LDH, and hybrid LDH materials of all nanomaterials incorporated into electrospun mats were tested against the ATCC cultures of gram-positive bacteria; Staphylococcus aureus (ATCC 25923), Bacillus subtilis (ATCC 49619), and gram-negative bacteria; Escherichia coli (ATCC 25922), Pseudomonas aeruginosa (ATCC BAA 1706). These bacteria are predominant pathogenic bacteria that can be commonly observed in food. Figure 9 shows the respective zones of inhibition against tested the bacteria. Considering the literature, Mumtaz et al have revealed the antibacterial activity of citric acid at various temperatures against gram-positive bacteria: Bacillus licheniformis, Staphylococcus aureus, and Bacillus subtilis and gram-negative bacteria: Proteus mirabilis, Klebsiella pneumoniae, Pseudomonas aeruginosa, and Escherichia coli [69]. Elif Ayşe Erdoğan Eliuz has also investigated the antibacterial properties of citric acid against E. coli, S. aureus, and C. albicans as a sanitizer agent [70]. Moreover, Song et al have reported the antibacterial effects of salicylic acid [21]. However, this is the first time reporting the synergistic antibacterial activity of all these antioxidants.
Figure 9. Disc diffusion assay for fabricated electrospun mats; (a) A graphical illustration of the inhibition zones of respective electrospun mats; (1) CA-LDH mat, (2) SA-LDH mat,(3) AA-LDH mat, (4) hybrid LDH mat, (b) The inhibition zones of; (i) Bacilus subtilis, (ii) Escherichia coli, (iii) Pseudomonas aureginosa, and (iv) Staphylococcus aureus; (+) Positive control, (-) Negative control, (1) CA-LDH, (2) SA-LDH, (3) AA-LDH, and (4) hybrid LDH mat.
Download figure:
Standard image High-resolution imageAccording to the reported results, all the antioxidants intercalated in electrospun mats show antibacterial activity against the tested bacteria. The hybrid LDH material intercalated LDH incorporated electrospun mats showed the best antibacterial activity against the tested bacteria. When analyzing the inhibition zones of the other discs (except the hybrid LDH material intercalated LDH incorporated electrospun mat), CA-LDH showed the minimum antibacterial activity, where AA-LDH incorporated electrospun mat showed the highest antibacterial activity. Table 2 shows the zones of inhibition against all four tested bacteria.
Table 2. The zones of inhibition against all four tested bacteria.
| Sample | Zones of inhibition (mm) | |||
|---|---|---|---|---|
| B. subtilis | E. coli | P. aeruginosa | S. aureus | |
| Positive control (Standard antibiotic) | 25.33 ± 0.56 | 23.33 ± 0.56 | 30.00 ± 0.00 | 25.00 ± 0.56 |
| Negative control (Cellulose acetate mat) | — | — | — | — |
| CA-LDH mat | 10.00 ± 0.00 | 9.33 ± 0.56 | 8.33 ± 0.56 | 11.00 ± 0.00 |
| SA-LDH mat | 11.67 ± 0.56 | 10.00 ± 0.00 | 9.00 ± 0.00 | 10.67 ± 0.56 |
| AA-LDH mat | 14.00 ± 0.00 | 14.67 ± 0.56 | 11.67 ± 0.56 | 13.00 ± 0.00 |
| Hybrid LDH material + CAc mat (Hybrid LDH mat) | 23.33 ± 0.56 | 20.00 ± 0.00 | 14.00 ± 0.00 | 22.33 ± 0.56 |
Considering the reported results, it can be clearly evidenced the synergistic activity of the combination of the nanohybrids. By utilizing two or more constituents in the most effective way feasible, synergistic interaction improves the antibacterial properties and lowers the dosages of the individual agents. This may ensure the quality of the food stuffs while reducing the harmful and toxic effects of the constituents when employing this stratagem of synergistic activity in food packaging. Furthermore, Sethunga et al have reported the synergistic activity of essential oils and oleoresins that were extracted from Cinnamomum zeylanicum (cinnamon), Syzygium aromaticum (clove bud) and Zingiber officinale (ginger) against a broad spectrum of microorganisms as food packaging materials while providing proofs for this stratagem of synergy [71].
Considering the aforementioned results, it can be clearly observed that synergism plays a significant role in food preservation. The main mechanism of spoilage of food refers to lipid oxidation. Throughout the lipid oxidation, lipids that are unsaturated experience radical-initiated oxidative degradation, one of the major problems with food waste. Unpleasant flavors, hazardous aldehydes, and the co-oxidation of proteins and color are the outcomes of lipid oxidation. The food and beverage industry employ a variety of antioxidant techniques to lower lipid oxidation and lengthen shelf life. For many years, researchers have combined antioxidants to create synergistic interactions that enhance oxidative stability. However, little is known about the underlying processes of the synergistic interactions amongst antioxidants, and they are rarely investigated. The main principles of antioxidant synergism that have been proposed are as follows: rejuvenation of an oxidized antioxidant through another substance; distinctions between antioxidant separation in both heterogeneous and homogeneous infrastructures; integrating metal chelating along with free radical scavenging endeavors to supply two distinct defense pathways; alongside development of additional antioxidant substances across oxidation, including phenolics, dimers, or adducts, and these can further prevent lipid oxidation. It is frequently challenging to forecast which antioxidant combinations will be effective in concert with one another in complicated food systems. Knowing the mechanisms underlying synergism can help the food industry construct antioxidant combinations that are more efficient at extending shelf life and preventing oxidative damage, as well as easy, quick, and accurate ways to identify and assess synergism [72].
Furthermore, the hybrid LDH material incorporated electrospun mat showed greater antibacterial activity against the gram-positive bacteria. This can be explained by the differences in the structure of the cell walls of gram-positive and gram-negative bacteria [73]. Gram positive bacteria have three layers in their cell walls, whereas gram negative bacteria have four layers in their cell walls [74]. Therefore, it is difficult to destroy the cell wall of gram-negative bacteria other than gram-positive bacteria. The minimum values of the inhibition zones were reported against Pseudomonas aeruginosa. It is considered a bacterium that is difficult to destroy because of its own antibacterial resistance mechanisms. Similar results have been investigated by Yapa et al in an investigation of synergistic activity of multi metallic nanohybrids. This study provides evidence for the aforementioned antibacterial properties against various bacteria [43].
3.7. Shelf life studies of antioxidant intercalated LDH incorporated electrospun mat CAc- (Hybrid LDH mat) applied cherry tomatoes
Cherry tomatoes were employed to test the practical applicability of this study. They were refrigerated and tested. Three samples were employed; control sample (only the cherry tomatoes without any electrospun mats), cherry tomatoes with CAc nanofiber mat and cherry tomatoes with hybrid LDH nanomaterial incorporated nanofiber mat. The combination of antioxidants intercalated LDH incorporated electrospun nanofiber mat was evaluated for its preservative qualities as the final optimized product of this study. This material was proven for best antibacterial activity; therefore, it was employed to investigate the practical applicability of the product as a food packaging material. For every trial, three cherry tomatoes (n = 3) were employed. Every single day, cherry tomatoes appeared to be shrinking. Cherry tomatoes kept more effectively when refrigerated because their texture remained firmer. The native cherry tomatoes were kept fresh and edible until the 17th day of the study. However, the cherry tomatoes that were placed with hybrid nanomaterial incorporated nanofiber mat showed a shelf life of 42 days while proving that it can be kept edible for 25 more days when comparing with the control samples (only the cherry tomatoes without any electrospun mats) and cherry tomatoes placed with CAc nanofiber mat. A similar study by Qui et al, have synthesized a nanohybrid LDH@PCA using layered double hydroxide (LDH) loaded with p-coumaric acid (PCA). In this study, PCA in PVA-LPs-LDH@PCA demonstrated sustained release properties, consistent with Avrami and Arabolic diffusion models, for up to 55 h [75].
During the duration of storage, the pH of cherry tomatoes with and without electrospun mats were increased (figure 10(a)). On the other hand, figure 10(a) indicates that the cherry tomatoes placed with nanohybrids incorporated electrospun mat had lower pH values than the other samples of cherry tomatoes, indicating a reduced metabolism. Thus, it may be concluded that the nanohybrid incorporated nanofiber mat prolonged the period of preservation of fruits by reducing the metabolism, minimizing pH increase, and slowing down the intake of organic acids. This behavior that we discovered in our investigation has also been shown in earlier research [37]. Moreover, Gomez et al have shown that there is a significant relationship between the pH and the food spoilage due to the microbial growth in food. Here they have used three essential oils as antioxidants that give the antimicrobial activity, and the effects of pH value and the protein content were reported [76].
Figure 10. Physiochemical parameters of the cherry tomato samples; (a) pH, (b) titratable acidity, (c) weight loss (%) and (d) firmness; (1) cherry tomatoes with nanohybrids incorporated electrospun mat, (2) cherry tomatoes with CAc electrospun mat and (3) cherry tomatoes without any electrospun mats (control).
Download figure:
Standard image High-resolution imageOrganic acids present in fruits are used in respiration along with other processes related to metabolism. Titratable acidity ought to consequently decrease during the course of the period of preservation. The change in titratable acidity during storage time is depicted in figure 10(b). The cherry tomatoes placed with nanohybrids incorporated nanofiber mat exhibit the highest retention of organic acids as well as the least amount of titratable acidity drop with prolonged storage than the other two samples. These results validate the efficacy of nanohybrids incorporated electrospun mat in maintaining organic acid content within fruit for a specific duration. In this instance, the nanohybrids incorporated electrospun nanofiber mat successfully lowers the atmospheric oxygen content, which is essential for the growth of bacteria [77].
As a result, it may cause cherry tomatoes to respire more slowly. All microbes are required to be able to detect and react to variations in both the internal and external quantities of protons. High proton concentrations result in acidic environments, and organisms must react accordingly to protect biomolecules and processes related to metabolism enough to sustain survival. While much has been discovered in recent decades regarding the strategies used by bacteria to withstand acid, including the particular difficulties posed by organic acids and the key molecular mechanisms known to be important for microbial survival during acid stress [78]. Nevertheless, weak organic acids, like lactate or acetate, may penetrate the lipid bilayer along with release their electrons in the environment inside the cell, during which the pH is frequently closer to neutral and higher than the pKa value associated with the acidic group. Mira and Teixeira have showed that these acids become protonated at low pH (depending on the pKa of their acidic groups) along with consequently uncharged which makes them more lipophilic. Although they can cause cytoplasmic acidification as well as collapse proton variations, organic acids pose a distinct risk to cells of microbes, particularly in situations while their extracellular environment is acidic [79].
Although cherry tomatoes are easily perishable fruits by nature, no matter how they are preserved, they will always tend to lose weight (figure 10(c)). However, compared to the cherry tomatoes group with nanohybrid incorporated mat, the control group's cherry tomatoes showed a more noticeable weight decrease. In comparison to the cherry tomatoes with nanohybrid incorporated mat, the control group of cherry tomatoes lost more weight. The impermeable qualities of packing materials account for the decrease in the weight loss rate experienced by the cherry tomatoes with nanofibers mats with antioxidant LDH as compared to the control group. The post-harvest weight loss was already reported by many researchers. Singh et al have reported on a post-harvest treatment including CaCl2, mustard oil and K2SO4 separately to reduce this weight loss [80]. Moreover, by a similar study of using tomatoes, Ruiz et al reported the reason for this weight loss is the decay of moisture content during the shelf life of tomatoes and they have invented a chitosan-Ruta graveolens (CS + RGEO) essential oil coatings to reduce this post-harvest weight loss [81].
The microbial colony counts were used to assess bacterial and fungal growth. During the course of the 42 days of refrigerated preservation, the microbial population was significantly reduced owing to the nanohybrids incorporated electrospun nanofiber mat (figures 11, 12 and 13). After 17 days, the spread of bacteria and molds were considerably high in the control samples of cherry tomatoes and cherry tomatoes placed with CAc mat. The cherry tomatoes kept with nanohybrids incorporated electrospun nanofiber mat showed a minimal bacterial growth compared to the other control samples (∼2.41 log CFU/ml). Regarding the growth of molds (figure 13(b)), it was discovered that the mold was growing quickly in the control samples, and by day 17, there were noticeably a reported growth of molds in the control samples (figures 11 and 12). By the conclusion of storage, all of the tomatoes kept with nanohybrids incorporated electrospun mat showed significantly fewer mold counts as compared to the control samples.
Figure 11. Images of the cherry tomatoes; (1) cherry tomatoes without any electrospun mats (control), (2) cherry tomatoes with CAc electrospun mat and (3) cherry tomatoes with LDH nanohybrids incorporated electrospun mat.
Download figure:
Standard image High-resolution imageFigure 12. Images of the colony count study; (1) cherry tomatoes without any electrospun mats (control), (2) cherry tomatoes with CAc electrospun mat and (3) cherry tomatoes with nanohybrids incorporated electrospun mat.
Download figure:
Standard image High-resolution imageFigure 13. (a) Log values of colony forming units of bacteria; (1)cherry tomatoes without any electrospun mats (control), (2) cherry tomatoes with CAc electrospun mat and (3) cherry tomatoes with nanohybrids incorporated electrospun mat; (b) colony forming units of molds; (1) cherry tomatoes without any electrospun mats (control), (2) cherry tomatoes with CAc electrospun mat and (3) cherry tomatoes with nanohybrids incorporated electrospun mat.
Download figure:
Standard image High-resolution imageBecause of the antibacterial component in the active packaging mats, cherry tomatoes with nanohybrids containing an electrospun nanofiber mat exhibited less mold and bacterial colonies. The growth of molds and other microorganisms in cherry tomatoes with nanohybrids incorporated electrospun nanofiber mat regularly dropped over preservation, while the spread of these organisms accelerated the development of microorganisms in unwrapped and wrapped cherry tomatoes with CAc electrospun nanofiber mat. The microbiological analysis and results demonstrate the nanohybrids incorporated electrospun nanofiber mat is efficient as an antibacterial packaging material that aids in limiting microbial growth and prolonging the duration of storage [82–85].
Numerous studies have thoroughly examined the mechanochemical characteristics of electrospun membranes based on cellulose acetate. It's perfect mechanochemical stability has been demonstrated through use in a variety of contexts. Its recovery and reutilization using simple mechanochemical treatment in a solid basic media has been demonstrated by Borges et al [86]. This process may hydrolyze acetate moieties and simultaneously reduce particle size. Furthermore, research by Shukla et al on a variety of cellulose acetate membrane mechanochemical characteristics has sped up the use of cellulose acetate-based polymer membranes in a variety of applications [87].
According to the Tarus et al, flexible packaging materials possess tensile properties that can be categorized as inferior (less than 1 MPa), marginal (1–10 MPa), good (10–100 MPa), or exceptional (more than 100 MPa). They have reported a tensile strength of 13 MPa exhibited by the electrospun cellulose acetate and poly(vinyl chloride) nanofiber mats containing silver nanoparticles in their study [88]. Regarding the DSC studies, Naragund et al have reported that cellulose acetate exhibited a glass transition temperature of 190 °C [89]. Similarly, Kramar et al have reported when blending cellulose acetate with other polymers or materials cause decreasing the glass transition temperature. The reported a glass transition temperature in a range of 184 °C–189 °C when cellulose acetate blending with poly ethylene glycol [90].
4. Conclusion
In the present study, we aimed to develop a polymer-based nanofiber mat supplemented with commonly used antioxidants that may be applied to food packaging. To ascertain the synergistic activity of three types of antioxidants, ascorbic acid (AA), salicylic acid (SA), and citric acid (CA), were utilized. The hybrid LDH material exhibited the highest antioxidant activity with an IC50 value of 132.5 μg ml−1, where 234.1, 354.5, and 402.2 μg ml−1 were reported for ascorbic-LDH, salicylic-LDH, and citric-LDH respectively. Considering the antibacterial potential, the hybrid LDH material incorporated nanofiber mat has showed a minimal bacterial growth compared to the other control samples (∼2.41 log CFU/ml). Finally, the fabricated mat showed an extended shelf life of 42 days for cherry tomatoes, whereas the control sample showed a shelf life of 17 days. It is concluded that hybrid LDH material exhibited synergistic performance and the best antioxidant activity when comparing with AA-LDH, CA-LDH, and SA-LDH materials.
The synergistic activity that is gained by a combination of overall activity of several antioxidants is the kingpin in this phenomenon. When considering the reported results, the intercalation to the LDH has ensured the slow release of the antioxidants and it is responsible for extending the shelf life of food. It is beneficial to develop this hybrid LDH material incorporated nanofiber mat as a potential food packaging as well. The simple fabricating technique of electrospinning and the apparently cost-effective antioxidants and LDH ensure an inexpensive, biodegradable, scalable, emerging food packaging material that possess an antibacterial potential. Here, we have tested by lining the fabricated mat at the bottom of the storing container. As a future prospect, this nanofiber mat can be developed as a whole wrapping material. It was tested for cherry tomatoes only, however, with these promising results this fabricated nanofiber material can be employed to preserve other fruits and vegetables too. Furthermore, this nanofiber membrane can be reinforced with sensors or AI tools that can detect the physiochemical parameters such as pH, firmness, and acidity etc.
Acknowledgments
Financial support for this study is acknowledged by the University of Sri Jayewardenepura, Sri Lanka under the research grant number ASP/ 01/ RE/ SCI/ 2022/ 15 and The World Academy of Science (20/102/ RG/ CHE/ AS_1-FR3240314134) for providing grants for the electrospinning setup.
Data availability statement
All data that support the findings of this study are included within the article (and any supplementary files).
Statements of declaration
The authors have no relevant financial or non-financial interests to disclose.
Compliance with ethical standards
The authors declare that there is no conflict of interest.